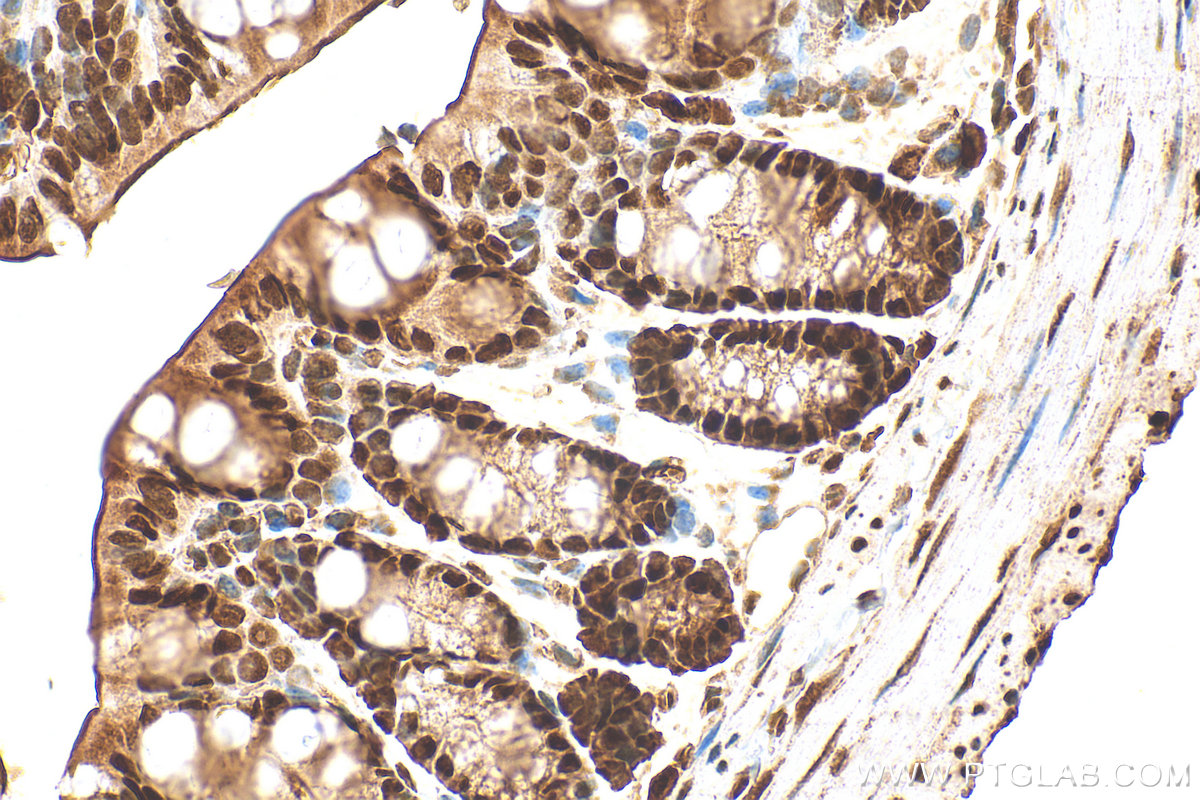
IHC staining of mouse colon using 10197-1-AP

验证数据展示
经过测试的应用
| Positive WB detected in | C6 cells, HeLa cells, mouse testis tissue, Jurkat cells, K-562 cells, NIH/3T3 cells |
| Positive IP detected in | HeLa cells |
| Positive IHC detected in | mouse colon tissue, human testis tissue Note: suggested antigen retrieval with TE buffer pH 9.0; (*) Alternatively, antigen retrieval may be performed with citrate buffer pH 6.0 |
| Positive IF/ICC detected in | HeLa cells |
推荐稀释比
| 应用 | 推荐稀释比 |
|---|---|
| Western Blot (WB) | WB : 1:8000-1:20000 |
| Immunoprecipitation (IP) | IP : 0.5-4.0 ug for 1.0-3.0 mg of total protein lysate |
| Immunohistochemistry (IHC) | IHC : 1:500-1:2000 |
| Immunofluorescence (IF)/ICC | IF/ICC : 1:200-1:800 |
| It is recommended that this reagent should be titrated in each testing system to obtain optimal results. | |
| Sample-dependent, Check data in validation data gallery. | |
产品信息
10197-1-AP targets HDAC1 in WB, IHC, IF/ICC, IP, CoIP, ChIP, ELISA applications and shows reactivity with human, mouse, rat samples.
| 经测试应用 | WB, IHC, IF/ICC, IP, ELISA Application Description |
| 文献引用应用 | WB, IHC, IF, IP, CoIP, ChIP |
| 经测试反应性 | human, mouse, rat |
| 文献引用反应性 | human, mouse, rat, pig |
| 免疫原 |
CatNo: Ag0256 Product name: Recombinant human HDAC1 protein Source: e coli.-derived, PGEX-4T Tag: GST Domain: 184-482 aa of BC000301 Sequence: EEAFYTTDRVMTVSFHKYGEYFPGTGDLRDIGAGKGKYYAVNYPLRDGIDDESYEAIFKPVMSKVMEMFQPSAVVLQCGSDSLSGDRLGCFNLTIKGHAKCVEFVKSFNLPMLMLGGGGYTIRNVARCWTYETAVALDTEIPNELPYNDYFEYFGPDFKLHISPSNMTNQNTNEYLEKIKQRLFENLRMLPHAPGVQMQAIPEDAIPEESGDEDEDDPDKRISICSSDKRIACEEEFSDSEEEGEGGRKNSSNFKKAKRVKTEDEKEKDPEEKKEVTEEEKTKEEKPEAKGVKEEVKLA 种属同源性预测 |
| 宿主/亚型 | Rabbit / IgG |
| 抗体类别 | Polyclonal |
| 产品类型 | Antibody |
| 全称 | histone deacetylase 1 |
| 别名 | EC:3.5.1.-, EC:3.5.1.98, GON 10, HD1, histone deacetylase 1 |
| 计算分子量 | 55 kDa |
| 观测分子量 | 60 kDa |
| GenBank蛋白编号 | BC000301 |
| 基因名称 | HDAC1 |
| Gene ID (NCBI) | 3065 |
| RRID | AB_2118062 |
| 偶联类型 | Unconjugated |
| 形式 | Liquid |
| 纯化方式 | Antigen affinity purification |
| UNIPROT ID | Q13547 |
| 储存缓冲液 | PBS with 0.02% sodium azide and 50% glycerol, pH 7.3. |
| 储存条件 | Store at -20°C. Stable for one year after shipment. Aliquoting is unnecessary for -20oC storage. |
背景介绍
Background
Histone Deacetylase 1 (HDAC1) is a nuclear localized class I histone deacetylase that plays a role in the regulation of gene expression, mainly by repression of gene activity. Additionally, HDAC can mediate deacetylation of a subset of non-histone proteins, leading to their degradation. HDAC1 activity has an impact on cell growth, proliferation, and death.
1. What is the molecular weight of HDAC1?
The molecular size of HDAC1 is 60 kDa.
2. What is the subcellular localization of HDAC1?
Unlike some HDACs, HDAC1 is present entirely in the nucleus. Our HDAC1 antibody has been broadly tested for IF/ICC.
3. I cannot detect an HDAC1 specific signal in my sample during western blotting.
Make sure that you efficiently extract nuclear proteins during your sample preparation. Some lysis buffers (e.g., based on Triton X-100) may not extract nuclear proteins. We recommend using RIPA buffer (https://www.ptglab.com/support/protocols/). We highly recommend using nuclear loading control antibodies, such as lamin B1 or PCNA (https://www.ptglab.com/news/blog/loading-control-antibodies-for-western-blotting/). Alternatively, you may consider performing cell fractionation.
4. How do I perform chromatin immunoprecipitation (ChiP) with the HDAC1 antibody?
We recommend using our standard chromatin immunoprecipitation protocol (https://www.ptglab.com/media/2708/web_chip-protocol.pdf).
5. Is HDAC1 post-translationally modified?
HDAC1 is a protein deacetylase but itself can also be a subject of post-translational modifications, including phosphorylation, acetylation, ubiquitination, SUMOylation, nitrosylation, and carbonylation (PMID: 21197454).
6. What is the role of HDAC1 in cancer?
The acetylation and deacetylation of histones play an important part in the epigenetic regulation of gene expression. Alterations in the balance between these two opposing processes changes chromosome remodeling and increased deacetylation leads to gene silencing. HDAC1 levels are increased in many cancer cell types and the role of HDAC1 in cancer is connected not only to histone deacetylation but also to the deacetylation of other proteins, such as Rb family proteins, estrogen receptors, and p53 protein (PMID: 19383284).
实验方案
| Product Specific Protocols | |
|---|---|
| IF protocol for HDAC1 antibody 10197-1-AP | Download protocol |
| IHC protocol for HDAC1 antibody 10197-1-AP | Download protocol |
| IP protocol for HDAC1 antibody 10197-1-AP | Download protocol |
| WB protocol for HDAC1 antibody 10197-1-AP | Download protocol |
| Standard Protocols | |
|---|---|
| Click here to view our Standard Protocols |
发表文章
| Species | Application | Title |
|---|---|---|
Acta Pharm Sin B Histone deacetylase inhibitors inhibit cervical cancer growth through Parkin acetylation-mediated mitophagy. | ||
J Clin Invest Acetaldehyde dehydrogenase 2 interactions with LDLR and AMPK regulate foam cell formation. | ||
Nat Commun PCGF6 controls neuroectoderm specification of human pluripotent stem cells by activating SOX2 expression. | ||
Nat Commun The methyltransferase METTL3 negatively regulates nonalcoholic steatohepatitis (NASH) progression. | ||
Hepatology PROX1 promotes hepatocellular carcinoma metastasis by way of up-regulating hypoxia-inducible factor 1α expression and protein stability. |